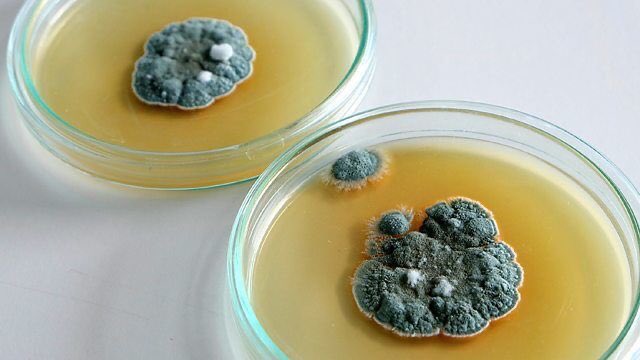

(ليس كل دواء طرح بالسوق بيوم وليلة
هناك مراحل وإخلاقيات في الاكتشاف)
وسويت هذا #الثريد الي راح يكون بعنوان:
(مراحل اكتشاف الدواء من العدم الى طرحه بالسوق)
هناك مراحل وإخلاقيات في الاكتشاف)
وسويت هذا #الثريد الي راح يكون بعنوان:
(مراحل اكتشاف الدواء من العدم الى طرحه بالسوق)
عناوين الثريد :
١-ماهي قصة الاطفال دون اطراف؟
٢-ايش هي ال selectivity الي منعت من اكتشاف العديد من الادوية؟
٣-ماهي مراحل الطور “phases”بعد اكتشاف المركب؟
٤-كم سنة تقريبا كافية لاكتشاف الادوية؟
٥- كم عدد ارباح الشركات من اكتشاف الادوية ؟
٦-شرح تأسيسي لإكتشاف الادوية؟
١-ماهي قصة الاطفال دون اطراف؟
٢-ايش هي ال selectivity الي منعت من اكتشاف العديد من الادوية؟
٣-ماهي مراحل الطور “phases”بعد اكتشاف المركب؟
٤-كم سنة تقريبا كافية لاكتشاف الادوية؟
٥- كم عدد ارباح الشركات من اكتشاف الادوية ؟
٦-شرح تأسيسي لإكتشاف الادوية؟
#اولا: قصة الاطفال بدون اطراف :
كان في قديم الزمن ليست هنالك تجارب سريرية لإكتشاف الادوية فكان الناس يتداولون الادوية ولا يعلمون موانع استخدام الادوية
(Contraindications/Warning)
ولا يعلمون الكثير من الاعراض الجانبية
فكانت هنالك حادثة في المانيا غيرت مجرى الطب
.... يتبع
كان في قديم الزمن ليست هنالك تجارب سريرية لإكتشاف الادوية فكان الناس يتداولون الادوية ولا يعلمون موانع استخدام الادوية
(Contraindications/Warning)
ولا يعلمون الكثير من الاعراض الجانبية
فكانت هنالك حادثة في المانيا غيرت مجرى الطب
.... يتبع
ماهي هذه الحادثة :
كان في المانيا يشاع ان لأول مررره هنالك دواء سحري ضد القيء يسمى #ثاليدومايد
فكانت النساء يتداولونه بكثرة بسبب معاناتهن مع القيء اثناء الحمل
وكان شبه سحري يذهب شعور القيء بعد تلقي هذه الامرأة الدواء
.... يتبع
كان في المانيا يشاع ان لأول مررره هنالك دواء سحري ضد القيء يسمى #ثاليدومايد
فكانت النساء يتداولونه بكثرة بسبب معاناتهن مع القيء اثناء الحمل
وكان شبه سحري يذهب شعور القيء بعد تلقي هذه الامرأة الدواء
.... يتبع
#ثانيا ايش هي ال selectivity الي منعت من اكتشاف العديد من الادوية؟
تقول الدراسات ان لكل تجربة على ١٠٠٠ دواء يتم اختيار دواء واحد من الالف دواء بسبب فشل هذه الادوية في اجتياز مراحل القبول من FDA وطرحه بالسوق
ومن اقوى الموانع هي الselectivity حقت الدواء
.... يتبع
تقول الدراسات ان لكل تجربة على ١٠٠٠ دواء يتم اختيار دواء واحد من الالف دواء بسبب فشل هذه الادوية في اجتياز مراحل القبول من FDA وطرحه بالسوق
ومن اقوى الموانع هي الselectivity حقت الدواء
.... يتبع
#ثالثا :ماهي مراحل الطور “phases”بعد اكتشاف المركب؟
الان انا اكتشفت نبات مثل نبات الشيح الي صنع منه دواء الملاريا
ايش التجارب preclinical و clinical الي راح يمر فيها دوائي الين يجيه القبول من FDA عشان يطرح بالسوق ..
يلا نتابع مرحله الين يطرح للسوق 👇🏻
الان انا اكتشفت نبات مثل نبات الشيح الي صنع منه دواء الملاريا
ايش التجارب preclinical و clinical الي راح يمر فيها دوائي الين يجيه القبول من FDA عشان يطرح بالسوق ..
يلا نتابع مرحله الين يطرح للسوق 👇🏻
قبل ما نقولكم الphases بعد حادثة ثاليدوامايد صارت دراسات واخلاقيات وصار في علم اسمه pharmacoveglance
التيقظ الدوائي يدرس اعراض الجانبية للدواء وو الخ
وصار فيها براهين واخلاقيات ومعاير امان قبل طرح الدواء للسوق
يلا نكمل الphases
التيقظ الدوائي يدرس اعراض الجانبية للدواء وو الخ
وصار فيها براهين واخلاقيات ومعاير امان قبل طرح الدواء للسوق
يلا نكمل الphases
#رابعا : كم سنة تقريبا كافية لاكتشاف الادوية؟
من ١٢ الى ١٧ سنه تاخذ من شركات الادوية هذه المراحل
بس ماسألتم نفسكم ليش ليش شركات الادوية تضخ فلوس وفي الاخير يمكن مايكتشف دواء؟
😂 لابد عندهم حركه يضخون فلوس في مايقارب ٢٠٠ اكتشاف واحد من ال٢٠٠ مو بس يعوض خسارتهم الا يدبل ربحهم اضعاف
من ١٢ الى ١٧ سنه تاخذ من شركات الادوية هذه المراحل
بس ماسألتم نفسكم ليش ليش شركات الادوية تضخ فلوس وفي الاخير يمكن مايكتشف دواء؟
😂 لابد عندهم حركه يضخون فلوس في مايقارب ٢٠٠ اكتشاف واحد من ال٢٠٠ مو بس يعوض خسارتهم الا يدبل ربحهم اضعاف
#خامسا - كم عدد ارباح الشركات من اكتشاف الادوية ؟
ناخذ مثلا دواء (Atorvastatin) ارباحه في الشهر مايقارب ٢ مليار 😅🤟🏻
وهذي قائمة لشركات ادوية الي اعلى ايرادات بالعالم عام ٢٠١٨
وكلها لها فروع بالسعودية ويستقطبون صيادلة
ناخذ مثلا دواء (Atorvastatin) ارباحه في الشهر مايقارب ٢ مليار 😅🤟🏻
وهذي قائمة لشركات ادوية الي اعلى ايرادات بالعالم عام ٢٠١٨
وكلها لها فروع بالسعودية ويستقطبون صيادلة
#سادسا : شرح تأسيسي لإكتشاف الادوية؟
هذا للي مهتمين بالكيمياء الدوائية واكتشاف الادوية ذا شرح تأسيسي
هذا للي مهتمين بالكيمياء الدوائية واكتشاف الادوية ذا شرح تأسيسي
#اخيرا حاولت قدر المستطاع الخص لكم اكتشاف الدواء من العدم الى طرحه بالسوق وان شاء الله استفدتم واستمتعم
من ناحية اذا بتتزودون بالمعلومات حول
Drug discovery:
@atiah1170
@alqahtani7m
الصناعة وشركات الادوية
@aalanazi
ال clinical trials:
@hashemalsaab
@AlthobaitiYusuf
@SAlmawash
من ناحية اذا بتتزودون بالمعلومات حول
Drug discovery:
@atiah1170
@alqahtani7m
الصناعة وشركات الادوية
@aalanazi
ال clinical trials:
@hashemalsaab
@AlthobaitiYusuf
@SAlmawash
جاري تحميل الاقتراحات...